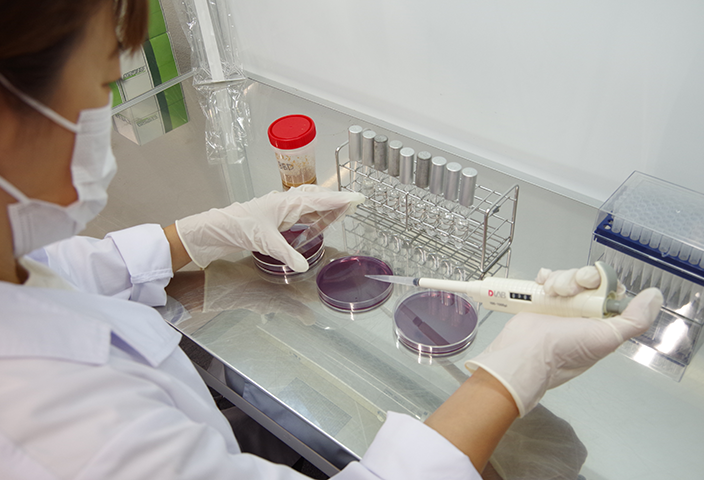

OUR WORKS
業務内容
01
乳酸菌製剤「バイオバランス®」の
製造・販売
バイオバランスに配合されている乳酸菌
家畜用の乳酸菌発酵飼料バイオバランス®に配合されている3種類の乳酸菌は、自社での研究により新たに発見された乳酸菌であり、世界各国で特許を取得しています。
Lactobacillus delbrueckii Anti muffa株 (ラクトバチルス デルブリッキー アンティムッファ株) この菌株は、有害カビ(特にアオカビ)に対する抗カビ活性を持つ世界にも類を見ない乳酸菌です。飼料に生えるカビの抑制が期待できます。当社が保有している3種類の乳酸菌の中で一番早く特許を取得しました。
Lactobacillus acidphilus 55株 (ラクトバチルス アシドフィルス 55株) この菌株は、家畜の腸管内に定着しやすい特徴を持つ腸管性乳酸菌です。非常に耐酸性に優れており消化液に影響されること無く腸に到達し、腸内環境を改善するために働きます。
Lactobacillus plantarum 11株 (ラクトバチルス プランタナム 11株) この菌株は、植物から分離された植物性乳酸菌です。過酷な環境下でも生育できる丈夫な乳酸菌で、食物繊維の分解能力に優れています。
特許紹介
3種類の乳酸菌は下記の特許を取得しています
- 1新規な乳酸菌(2004-059912)
- 2飽和脂肪酸の摂取量を抑えることができる畜肉の製造方法(2017-537789)
- 3バイオバランス(登録商標)Yを利用した堆肥及びその製造方法(2016-548540)
- 4悪臭低減方法(2017-537790)
- 5肉質改良法(2017-537788)
世界12ヵ国で特許を取得しています
日本
韓国
中国
アメリカ
カナダ
ニュージーランド
オーストラリア
EU諸国
バイオバランス®の効果
- 家畜の健康
腸内細菌叢を変化させることにより、家畜の健康を促します
- 悪臭低減
未消化物の減少、糞の物性改善が期待できます
- 品質向上
飼料効率および肉質・乳質の向上が、日本を含む世界の農業主要国で認められています
- 省力化
床出しの回数が減り、労働時間の短縮が期待できます
- 堆肥の活用
微生物叢に着目した発酵様式を取り入れ、短期間で良質な堆肥に仕上げます
カタログダウンロードはこちらから
02
乳酸菌の管理・研究
各種分析
乳酸菌の管理
当社の研究所では、バイオバランス®に配合されている乳酸菌の培養及び製品の品質検査を行っています。
乳酸菌を培養する際は、雑菌の混入(コンタミネーション)を防ぐために器具や手指の消毒を徹底的に行い、汚染源の排除に努めています。

研究
- 2002年
- 抗カビ性を持つ乳酸菌Anti-muffa株を世界で初めて発見し特許を取得
- 2006年
- 岡山県立高松農業高等学校と採卵鶏に対するバイオバランス®の給与効果を研究
- 2007年
- 壇國大学校(大韓民国)と養豚に対するバイオバランス®の給与効果を研究
- 2015年
- メッシーナ大学(イタリア)と肉牛に対するバイオバランス®の給与効果を研究
各種分析
当社ではバイオバランス®の効果を確認するために微生物検査を中心とした各種分析を行っています。
飼料や堆肥、畜糞などの検体を扱っており、生物性や化学性を分析することができます。
実際にご依頼いただいたお客様からは、検体の性状を可視化できたとご好評いただいています。
03
牧場調査
堆肥・農作物生産・流通のプロデュース
牧場調査
当社では必要に応じて牧場に足を運び、製品の効果を最大限に引き出すための使用方法をご案内させて頂きます。また、各牧場の設備や経営状況、直面している課題にあわせた製品の活用方法をご提案します。
堆肥・農作物生産・流通のプロデュース
畜産農家や野菜農家が抱える課題解決に取り組み、耕畜連携の新しい農業ビジネスモデルを構築しています。
また近年は、全国各地で勉強会や牧場・圃場視察を開催し、幅広い業種の方々と交流を行っています。






